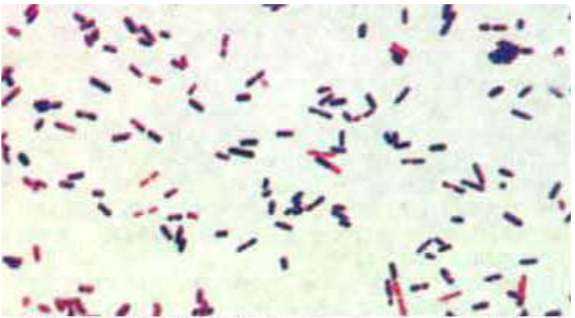
<p>spore forming - survive indefinitely&nbsp;</p><p>resistant to heat and cold</p><p>resistant to many disinfectants&nbsp;</p>

Equine Infectious Gastrointestinal diseases
1/27
There's no tags or description
Looks like no tags are added yet.
Name | Mastery | Learn | Test | Matching | Spaced |
|---|
No study sessions yet.
28 Terms
infectious causes of equine GI disease
Salmonella spp.
• Clostridium perfringens & Clostridium difficile
• Equine Coronavirus
• Rotavirus (foals)
• Ehrlichia risticii –Potomac Horse Fever
Biosecurity hazard
admission policy - policy is not to admit any horse with a high suspicion of having infectious colitis in a hospital without an appropriate isolation facility
when referring veterinarian has established that a horse has any 2 of the following 3 clinical signs =
acute diarrhoea
fever
low white blood cell count
case needs full isolation in a dedicated isolation facility
equine isolation unit - entering

salmonella - enterocolitis and diarrhoea
salmonella enterica
6 subspecies esp salmonella enterica aubsp enterica
over 2000 serovars esp typhimurium
other incl newport, anatum and agona
host specific cause more systemic disease
salmonella - host-pathogen and environment interactions - pathogen
gram -ve motile bacillus
modified flagellae and pilli used for plasmid exchange
facultative anaerobe
facultatively intracellular esp pathological strains
wide range of antibiotic resistance
adhesion molecule - 3 different types
invasion genes - encode proteins that cause ruffles in enterocyte membrane and salmonellae become interiorized
salmonella virulence plasmids - allow for intracellular growth, serum resistance and cellular invasion
3 exotoxins that all result in diarrhoea - cAMP, cytotoxin, phospholipase A activity
salmonella risk factors - host
Antibiotic treatment
• General anaesthesia
• Transport
• Competition
• Hospitalisation
• Surgery
• Feed withdrawal, change in feed
• Anthelmintic treatment
• Suppression of gastric acid?
• ANY STRESS
salmonella - host response
without invasion theres no response
lipopolysaccharide triggers massive neutrophil dominated inflammatory cascade
LPS → macrophage → IL-1 and TNF → neutrophil activation
persistence of facultative intracellular pathoggen in macrophages maintains inflammatory reaction
inflammation and tissue necrosis lead to leakage of protein and fluid → diarrhoea
exotoxins exacerbate inflammation and necrosis and promote more diarrhoea
systemic inflammatory response syndrome(SIRS) aka endotoxaemia
low arterial blood pressure is major part of pathology due to =
fluid loss - diarrhoea, oedema
widespread/ dysregulated vasodilation - ABP = CO x SVR, reduced venous return to heart
multiorgan failure - incl. heart, CO = HR x SV
salmonella - hosr response
diarrhoea dilutes salmonella and toxins and removes them from body
diarrhoea and endotoxaemia leads to severe shock adn cardio-circulatory collapse
variable mortality - if hydration can be maintained diarrhoea and inflammation response eliminates infection and mucosa heals
salmonella - host-pathogen and environment interactions - environment
survuve in damp soil up to 9 months
contagious - spread by direct contact and fomites
water and feed contaminated with faecal material
recovered animals may be shed for wks or months
host stress increases susceptibility and lowers required spore dose
most frequently reported outbreaks are among hospitalised patients
good for management and hygiene is effective control
salmonella - control and prevention - personal
gloves, shoe covers and outer protective clothing must be put on before entering stable
gloves, show covers and outer protective clothing must be removed upon leaving stable and boots dipped before leaving isolation area
washing hands after working with horses is essential - appropriate technique, antibacterial soap
salmonella - control and prevention - stable
• Horses in isolation should be mucked out last to avoid spreading faecal contamination to neighbouring stables
• Soiled bedding and feed from isolated cases should be bagged and disposed of as clinical waste (do not compost)
• After the horse has been discharged the stable should be completely emptied, with all bedding, waste feed and disposable protective clothing being disposed of as clinical waste
• Other equipment from the stable should be rinsed to remove visible faecal contamination and then cleaned thoroughly with Bleach (hypochlorite) or Virkon and dried completely
• The stable should be steam cleaned or scrubbed with detergent to remove visible faecal contamination from the walls and then sprayed with bleach (0.5%) and left for 10 min then rinsed and the walls and floor sprayed with Virkon S (1%) and left 10 min, the stable rinsed and excess water removed.
• The stable should then be swabbed for bacterial culture and then left empty to dry completely
• If the culture results identify persistent contamination then the stable should be cleaned with Bleach (hypochlorite) or Virkon and then steam cleaned again, before repeating swabs.
• Once culture results suggest that the stable has been sufficiently disinfected, then it may be used for new admissions
how long does horse need to stay in isolation
until 5 consecutive faecal cultures for salmonella(q12-24hrs) are negative
salmonella - control and prevention
ensure safety of food and water sources
quarantine newly admitted horses for 10 days
avoid crowding
avoid rapid changes in diet
remove from pasture
barrier nurse at risk horses
zoonotic
other differential diagnosis for acute diarrhoea/ colitis
colostridium perfringens and clostridium difficile
acute necrotic colitis and dysentery
equine coronavirus
rotavirus - acute enterocolitis in foals
ehrlichia resticii - potomac horse fever
cyathastomiasis
right dorsal colitis
clostridium perfringens and clostridium difficile colitis
saprophytic and part of normal intestinal flora
large gram +ve endospore forming bacilli
obligate anaerobes and haemolytic in culture
C. perfirnges - non-motile
C.difficile - motile
also C. septicum and sordellii
clostridium difficile - host-pathogen and enviroment interactions - pathogen
C. perfringens type A is most common in horses
Enterotoxin –cytotoxic
Alpha toxin –lecithinase (phospholipase activity)
β2-toxin (toxigenic strain)
C. difficile –Toxin A & B
proinflammatory (IL-1 & TNF)
toxic to macrophages
clostridium difficile - host-pathogen and enviroment interactions - host
part of normal flora
requires host stress or intestinal flora change
high mortality rates
good management and hygiene is usually effective control
C. difficile is significant cause of diarrhoea in people - CDAD
stress factors
intercurrent infections
extreme temp
water deprivation
over crowding
sudden change in diet
antibiotic therapy
general anaesthesia
clostridium difficile - host-pathogen and enviroment interactions - environment
spore forming - survive indefinitely
resistant to heat and cold
resistant to many disinfectants
Clostridium perfringens & Clostridium difficile colitis - Diagnosis
culture is not reliable - part of normal flora and not all isolates are toxigenic
identification of C.perfringens enterotoxin or Beta2 toxin by ELISA or toxogenic genes by PCR
identification of C. difficile toxin A or B by ELISA or toxogenic genes by PCR
prevention and management a
void crowding and stress
avoid rapid changes in diet
quarantine affected animals
barrier nurse
dispose of soiled bedding carefully
change outer clothing
wash hands
equine coronavirus
can cause anorexia, fever, lethargy and colitis - often with lymphopaenia and neutropaenia
testing now comercially available - PCR faeces
low mortality - incl in miniature breeds
varibale morbidity
rotavirus - young(<2 months) foals
• Genus of the family Reoviridae (as is AHS & Blue Tongue)
• Multiple strains & serotypes (range of virulence)
• Strains appear to be predominantly host species specific
• Coat protein VP4 is the haemagglutinin that dictates species susceptibility
• VP4 protein - target antigen of neutralising antibody response
Rotavirus: Host-pathogen and environment interactions: pathogen
• Virus is ingested and infects the absorptive epithelium of the apices of the villi
• Mostly the small intestine is involved (occasionally colon)
• Damage and loss of cells in villi leads to villus atrophy, resulting in poor nutrient absorption and osmotic diarrhoea
• Virulent strains cause more necrosis and haemorrhage
• Humoral response by the host neutralizes virus
• Incubation period 18-24 hours
• Disease course is usually 5-7 days (self limiting)
• Recovered foals shed for 2 weeks
Rotavirus: Host-pathogen and environment interactions: host
most common infectious diarrhoea of horses
recovered animals may shed for weeks
host stress increases susceptibility
low mortality but can be high morbidity
age less than 2 months
intercurrent infections
extreme temperature
poor food and water sanitation
overcrowding
transportation
high levels of infection on property in previous yr
stressed adult horses may intermittently shed
Rotavirus: Host-pathogen and environment interactions: environment
contagious - spread by direct contact and fomites
water and feed contaminated with faecal material
survive in environment up to 9 months
resistant to bleach disinfectant - ethanol, phenols and formalin can inactive the virus
good management and hygiene is effective control
rotavirus diagnosis
clinical signs and identification of virus in faeces
PCR - rotavirus type A and B
electronmicroscopy - latec aggultination or ELISA field test
must rule out concurrent disease
rotavirus - control and prevention
• Ensure clean food and water sources
• Avoid crowding foals together
• Clean foal bedding frequently
• Isolate severely affected foals
– Barrier nurse
– Wash hands
– Change outer garments
• Vaccination Equine Rotavirus vaccine (Zoetis)
– Mare in 8th , 9th & 10th months of EACH pregnancy
– Relies on good passive transfer and protects for approximately 60 days